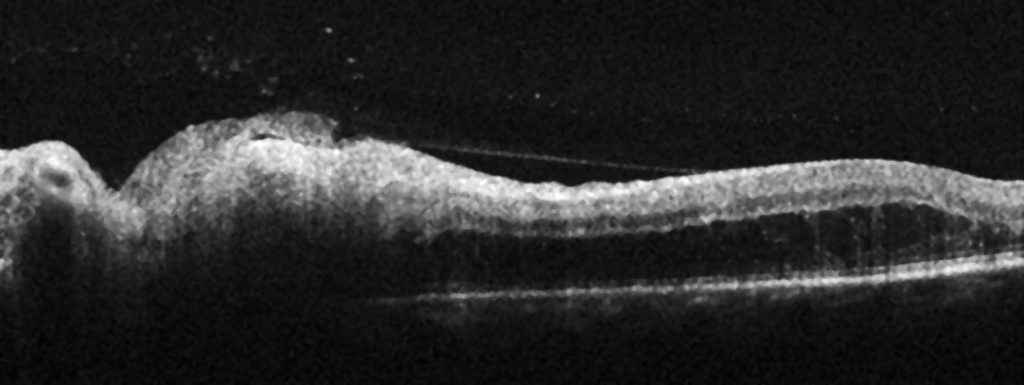
Figure 2 Radial OCT through the optic disc (to the left) and nasal macula (fovea to the right). Thickening of the inner&hellip;

A woman in her forties with unilateral blurred vision and pain upon eye movement
A woman in her forties presented with subacute onset of unilateral blurred vision with pain upon eye movement. Although findings from MRI and cerebrospinal fluid analysis were typical of demyelinating disease, the final diagnosis was a condition requiring an entirely different therapeutic approach.
A previously healthy woman in her forties sought medical attention after three days of blurred vision in her left eye. This had been accompanied by mild headache and transient retrobulbar pain exacerbated by eye movements.
Unilateral subacute vision loss with retrobulbar, movement-related pain in a relatively young and previously healthy woman is suggestive of demyelinating optic neuritis.
The patient, who had no previous history of neurological symptoms, was referred for outpatient ophthalmological assessment.
Ophthalmological assessment revealed a normal right eye. Best-corrected visual acuity in the left eye was 0.75, and the patient had no subjective impairment in colour vision. No afferent pupillary defect was described, and the anterior segment was normal. The view of the posterior segment was slightly obscured by cells in the vitreous. Optic disc swelling was observed, with a diffuse infiltrate on the temporal side (Figure 1a).

Optical coherence tomography (OCT) of the left optic disc showed thickening of the peripapillary retinal nerve fibre layer with an average thickness of 159 µm (> 95 % reference range) (Figure 2). A thickening of the inner retinal layers was also seen, corresponding to the temporal infiltrate.
Unilateral optic disc swelling is suggestive of optic neuropathy, and strengthens suspicion of a demyelinating optic neuritis with involvement of the optic disc. However, there were two 'red flags', or findings that were not typical of demyelinating optic neuritis: the presence of cells in the vitreous and the peripapillary infiltrate (1, 2). These findings led us to consider other possible causes of optic neuritis with optic disc involvement Box 1) ((1, 3).
Neuromyelitis optica spectrum disorders
Anti-myelin oligodendrocyte glycoprotein (MOG)-associated optic neuritis
Acute disseminated encephalomyelitis
Sarcoidosis
Systemic lupus erythematosus
Behçet's disease
Sjögren's syndrome
Chronic relapsing inflammatory optic neuropathy (CRION)
Infections
Parainfectious optic neuritis
MRI of the head/orbits with contrast showed normal optic nerves and no signs of retrobulbar pathology. A periventricular hyperintensity with typical demyelinating features was seen (Figure 3), along with small, non-specific, rounded hyperintensities in frontal and parietal regions of the right hemisphere (Figure 3). None of the lesions were contrast-enhancing, which would have been a sign of active inflammation.

The periventricular hyperintense lesion seen on MRI suggested demyelinating disease. However, there was no sign of inflammation of the optic nerve, which would be expected in a case of demyelinating optic neuritis. A peripapillary infiltrate and cells in the vitreous could indicate ocular toxoplasmosis (2). However, there was no evidence on the MRI to suggest a Toxoplasma infection of the central nervous system, which would typically result in multiple contrast-enhancing lesions and perifocal oedema (4). We therefore suspected that the patient may have two conditions: an ocular toxoplasmosis, which would explain the symptoms, and an additional subclinical demyelinating disease.
Serological testing revealed Toxoplasma gondii IgM and IgG antibodies with a high IgM/IgG index and low IgG avidity. Tests for IgG antibodies against varicella-zoster virus (VZV) and cytomegalovirus (CMV) were also positive, with borderline results for Borrelia burgdorferi and cytomegalovirus. Negative results were obtained for Treponema pallidum total antibody, varicella-zoster virus IgM and herpes simplex virus 1 + 2 IgM and IgG antibodies.
The IgG antibodies against varicella-zoster virus and cytomegalovirus suggested past infections. The borderline results for Borrelia burgdorferi and CMV-IgM were interpreted as non-specific findings, because neither the clinical nor MRI results were consistent with these diagnoses.
On suspicion of toxoplasmosis-related papillitis, the patient was started on peroral azithromycin (500 mg as a single dose) and clindamycin (300 mg × 3 daily). She was also given an intravitreal injection of clindamycin (1 mg) the following day.
The retrobulbar pain disappeared after a few days. After a week of treatment, the patient also experienced some improvement in vision, and her best corrected visual acuity was 0.8. On examination, there were still some cells in the vitreous, but the temporal peripapillary infiltrate was slightly smaller and more sharply defined. A second intravitreal injection of clindamycin was administered. After another week of treatment, best corrected visual acuity was 1.0. The infiltrate had become even smaller, and OCT showed normalisation of the peripapillary retinal nerve fibre layer, with an average thickness of 118 µm (within the 95 % reference range). The patient received a third and final intravitreal injection of clindamycin.
Six weeks later, the patient was virtually symptom-free. Best corrected visual acuity in the left eye was now 1.25, and the temporal peripapillary infiltrate had disappeared (Figure 1b).
Although the test results and treatment response both indicated that toxoplasmosis was the cause of the patient's symptoms, the findings on MRI strongly suggested that the patient also had a demyelinating disease. A lumbar puncture was therefore performed. Cerebrospinal fluid analysis revealed slightly elevated levels of protein at 0.58 g/L (reference range 0.15–0.50) and albumin at 515 mg/L (0–350), but a normal albumin index of 6.6 (0–9), IgG index of 0.56 (< 0.70) and cell count (< 5). Isoelectric focusing revealed oligoclonal IgG bands in the cerebrospinal fluid but not in the serum, indicating intrathecal IgG production. PCR testing for T. gondii was negative, as were antibody tests for IgM and IgG against B. burgdorferi.
Although infections and various inflammatory disorders of the central nervous system can give rise to oligoclonal bands in the cerebrospinal fluid but not the serum, the most common cause by far is multiple sclerosis (MS). Demyelinating optic neuritis is often the first manifestation of this disease, and visual evoked potentials (VEPs) remain prolonged for more than six months in 60–80 % of cases (5). Our patient was therefore referred for VEP testing nine months after symptom onset.
Visual evoked potentials occurred at a normal latency in both eyes, with no sign of the reduced conduction velocity that would otherwise indicate demyelination.
These findings thus supported our assumption that another condition was causing the patient's symptoms.
Three years later, the patient has not developed either clinical or radiological signs of multiple sclerosis. She has had no recurrence of the toxoplasmosis, but has developed elevated intraocular pressure in her left eye, which is treated with selective laser trabeculoplasty and timolol eye drops.
Elevated intraocular pressure is a known complication of ocular toxoplasmosis (6). Ocular toxoplasmosis can also lead to retinal tears, retinal detachment, inflammatory macular oedema, optic nerve atrophy, cataracts, retinal vessel occlusion, and choroidal neovascularisation (6).
Toxoplasmosis serology was repeated 4 and 12 months after symptom onset. Both IgM and IgG for T. gondii remained positive, but with decreasing titers.
T. gondii-IgM antibodies are produced during the first week of infection and reach peak titer after 1–6 months; their levels then decline, but in most cases remain detectable for over a year (7). T. gondii-IgG can be detected 1–3 weeks after IgM antibodies become detectable. The IgG titer levels off after 2–3 months, before gradually decreasing to a level that remains stable throughout life, but that varies between individuals (7). IgM and IgG levels may increase upon reactivation of the disease (7). Less than 0.5 % of the population in Norway have T. gondii-IgM antibodies (8); in most immunocompetent individuals a positive test is a sign of a previous asymptomatic infection, but it can also be a false positive (9). IgM antibodies per se therefore cannot be used for diagnosis.
Discussion
The two differential diagnoses in our patient were demyelinating optic neuritis and ocular toxoplasmosis with papillary involvement. Making the correct diagnosis had significant therapeutic implications. High-dose corticosteroids may improve the course of a demyelinating optic neuritis, but may exacerbate toxoplasmosis. Moreover, a patient with demyelinating optic neuritis with IgG bands in the cerebrospinal fluid and a demyelinating lesion in the brain would have been advised to begin long-term immunomodulatory therapy to prevent conversion to MS. Although the symptoms, as well as the MRI and cerebrospinal fluid findings all pointed to demyelinating disease, ophthalmological findings suggested ocular toxoplasmosis. Normal findings on MRI of the optic nerve and a normal VEP test also supported the diagnosis of toxoplasmosis, as did positive serology (3, 6, 10, 11).
T. gondii is a very common parasite worldwide, especially in warmer climates (12). Cats are the primary host of the parasite (12), which releases eggs that can be ingested by birds and most mammals, including humans. Infection occurs through consumption of undercooked meat or unwashed fruits and vegetables, or through contact with faeces from infected cats. Infections are usually asymptomatic or mild, but immunocompromised individuals may develop serious manifestations such as encephalitis (12). Infection during pregnancy can lead to miscarriage or serious birth defects such as hydrocephalus, vision loss and mental retardation (12).
Ocular toxoplasmosis is essentially a clinical diagnosis. T. gondii-IgG is usually present (6, 10), but the disease may also be the result of a past infection. While the prevalence of ocular toxoplasmosis is relatively low in Norway, a population-based study detected T. gondii-IgG in 10 % of pregnant women (13). A positive T. gondii-IgM test supports the diagnosis, but is not always seen because acute disease can also result from reactivation (2, 6, 10). T. gondii-IgG avidity testing can be used to distinguish between acute, chronic and past toxoplasma infections. Avidity is a measure of the functional affinity, or total binding strength, between an antibody and antigen (9). IgG avidity typically increases over time, and high IgG avidity therefore rules out an acute toxoplasma infection (infection during the last 3–4 months) with a high degree of certainty (9). Our patient had low IgG avidity, which together with the high IgM/IgG ratio, indicated an acute infection (9).
There is a lack of consensus over the optimal treatment for ocular toxoplasmosis (2, 6, 10). Antiparasitic treatment is recommended in cases with involvement of the optic disc, macula or retinal vessels, or where there are multiple or large lesions (2, 10). International recommendations favour the use of oral sulfadiazine and pyrimethamine, with the addition of corticosteroids if indicated (6, 10).
Sulfadiazine and pyrimethamine are not marketed in Norway and are rarely used because of their side effect profiles, and because of the teratogenicity of pyrimethamine (2). The Norwegian Ophthalmological Society instead recommends oral clindamycin and azithromycin, with the addition of corticosteroids in cases of more pronounced vitritis (2). The duration of treatment is determined by the clinical presentation. For recurrent infections, long-term systemic therapy may be required, such as a trimethoprim-sulfonamide combination (2). Intravitreal clindamycin, which was used in the current patient, is also likely to be effective (14, 15), but the evidence base is relatively limited (2, 10). The treatment may cause retinal toxicity and should be administered in collaboration with an ophthalmologist with relevant experience (10).
Ocular toxoplasmosis can affect both immunocompetent and immunodeficient individuals (6, 10). Toxoplasmosis is relatively common in immunocompetent individuals worldwide (16), and our patient had no immune deficiency.
Demyelinating optic neuritis is a frequent manifestation of multiple sclerosis. The condition is usually retrobulbar and is often without ophthalmoscopic findings in the acute stages (mild optic disc swelling is present in about one-third of cases): as the old adage goes, "the patient sees nothing, and the doctor sees nothing" (17). Demyelinating optic neuritis occurs most frequently in women aged 18–50 years. Typical early symptoms are mild to moderate retrobulbar pain exacerbated by eye movements, and the onset of blurred vision over hours to days. Examination often reveals vision loss with deficits in colour vision (dyschromatopsia), accompanied by a relative afferent pupillary defect (1, 18). The natural disease course is usually gradual spontaneous improvement. Red flags that may indicate an alternative aetiology are general malaise, young or advanced age, insidious onset, progressive course, pronounced pain or no pain at all, bilateral involvement, severe optic disc swelling and, as in the current patient, concomitant uveitis or neuroretinitis (1, 18, 19).
No definite association has been established between multiple sclerosis and toxoplasmosis (20), but the two conditions do share certain similarities, in that both can result in uveitis and optic neuritis (10, 21). The Norwegian ophthalmologist Marius Haarr was among the first to describe the association between multiple sclerosis and retinal periphlebitis. In 1951, he defended the first Norwegian doctoral thesis on the topic (22, 23). However, MS-associated uveitis is uncommon and rarely affects the posterior vitreous and optic disc, whereas both were affected in our patient (21).
This case history is an example of how a brain MRI can reveal signs of demyelinating disease in patients without clinical symptoms. This phenomenon, known as radiologically isolated syndrome, poses a significant therapeutic dilemma because about one-third of these patients will experience an episode of MS within five years (23). The presence of lesions in the spinal cord or oligoclonal IgG bands in the cerebrospinal fluid increases this risk significantly (24). Our patient did not fulfil the radiological McDonald criteria (dissemination in time and place) for multiple sclerosis, either initially or upon subsequent examination, and nor did she have spinal cord lesions. We chose therefore to continue with observation without initiating immunomodulatory therapy.
Atypical optic neuritis has been discussed in several previous case reports (1, 19, 25) and in a review article in the Journal of the Norwegian Medical Association (18). This case report illustrates the importance of remaining vigilant to possible differential diagnoses and of thorough interdisciplinary assessment, including in patients with symptoms and findings from MRI and cerebrospinal fluid analysis that may indicate demyelinating optic neuritis.
The patient has consented to the publication of this article. The article has been peer-reviewed.
- 1.
Ødegaard EM, Jørstad ØK, Kerty E. A teenager with acute bilateral visual loss. Tidsskr Nor Legeforen 2018; 138. doi: 10.4045/tidsskr.17.0802. [PubMed][CrossRef]
- 2.
Brandser R, Berg K. Uveitt. I: Kjeka O, Gupta R, Askim A, red. Nasjonal kvalitetshåndbok for oftalmologi. Oslo: Norsk oftalmologisk forening, 2017.
- 3.
Miller N, Subramanian P, Patel V. Walsh & Hoyt's Clinical Neuro-Ophthalmology: The Essentials. 3. utg. Philadelphia, PA: Wolters Kluwer/Lippincott Williams & Wilkins, 2015.
- 4.
Benson JC, Cervantes G, Baron TR et al. Imaging features of neurotoxoplasmosis: A multiparametric approach, with emphasis on susceptibility-weighted imaging. Eur J Radiol Open 2018; 5: 45–51. [PubMed][CrossRef]
- 5.
Frederiksen JL, Petrera J. Serial visual evoked potentials in 90 untreated patients with acute optic neuritis. Surv Ophthalmol 1999; 44 (suppl 1): S54–62. [PubMed][CrossRef]
- 6.
Butler NJ, Furtado JM, Winthrop KL et al. Ocular toxoplasmosis II: clinical features, pathology and management. Clin Exp Ophthalmol 2013; 41: 95–108. [PubMed][CrossRef]
- 7.
Robert-Gangneux F, Dardé ML. Epidemiology of and diagnostic strategies for toxoplasmosis. Clin Microbiol Rev 2012; 25: 264–96. [PubMed][CrossRef]
- 8.
Bigna JJ, Tochie JN, Tounouga DN et al. Global, regional, and country seroprevalence of Toxoplasma gondii in pregnant women: a systematic review, modelling and meta-analysis. Sci Rep 2020; 10: 12102. [PubMed][CrossRef]
- 9.
Montoya JG, Liesenfeld O. Toxoplasmosis. Lancet 2004; 363: 1965–76. [PubMed][CrossRef]
- 10.
Garweg J, Petersen E. Toxoplasmosis: Ocular disease. UpToDate. https://www.uptodate.com/contents/toxoplasmosis-ocular-disease Accessed 9.2.2021.
- 11.
Kupersmith MJ, Alban T, Zeiffer B et al. Contrast-enhanced MRI in acute optic neuritis: relationship to visual performance. Brain 2002; 125: 812–22. [PubMed][CrossRef]
- 12.
Folkehelseinstituttet. Toksoplasmose – veileder for helsepersonell. https://www.fhi.no/nettpub/smittevernveilederen/sykdommer-a-a/toksoplasmose---veileder-for-helsep/ Accessed 9.2.2021.
- 13.
Findal G, Barlinn R, Sandven I et al. Toxoplasma prevalence among pregnant women in Norway: a cross-sectional study. APMIS 2015; 123: 321–5. [PubMed][CrossRef]
- 14.
Soheilian M, Ramezani A, Azimzadeh A et al. Randomized trial of intravitreal clindamycin and dexamethasone versus pyrimethamine, sulfadiazine, and prednisolone in treatment of ocular toxoplasmosis. Ophthalmology 2011; 118: 134–41. [PubMed][CrossRef]
- 15.
Baharivand N, Mahdavifard A, Fouladi RF. Intravitreal clindamycin plus dexamethasone versus classic oral therapy in toxoplasmic retinochoroiditis: a prospective randomized clinical trial. Int Ophthalmol 2013; 33: 39–46. [PubMed][CrossRef]
- 16.
Greigert V, Bittich-Fahmi F, Pfaff AW. Pathophysiology of ocular toxoplasmosis: Facts and open questions. PLoS Negl Trop Dis 2020; 14: e0008905. [PubMed][CrossRef]
- 17.
Miller N, Newman N, Biousse V et al. Optic neuritis. I: Walsh and Hoyt's Clinical Neuro-Ophthalmology: The Essentials. 2. utg. Philadelphia, PA: Wolters Kluwer/Lippincott Williams & Wilkins, 2008.
- 18.
Dalbro SEJ, Kerty E. Atypisk optikusnevritt. Tidsskr Nor Legeforen 2019; 139. doi: 10.4045/tidsskr.18.0967. [PubMed][CrossRef]
- 19.
Sand MK, Stubhaug TT, Jørstad ØK. Atypical optic neuritis. Tidsskr Nor Legeforen 2017; 137: 731. [PubMed][CrossRef]
- 20.
Saberi R, Sharif M, Sarvi S et al. Is Toxoplasma gondii playing a positive role in multiple sclerosis risk? A systematic review and meta-analysis. J Neuroimmunol 2018; 322: 57–62. [PubMed][CrossRef]
- 21.
Messenger W, Hildebrandt L, Mackensen F et al. Characterisation of uveitis in association with multiple sclerosis. Br J Ophthalmol 2015; 99: 205–9. [PubMed][CrossRef]
- 22.
Haarr M. Periphlebitis retinae – en klinisk undersøkelse. Oslo: Akademisk trykningssentral, Blindern, 1951.
- 23.
Holmøy T, Jørstad ØK. The first Norwegian doctorate in multiple sclerosis. Tidsskr Nor Legeforen 2021; 141. doi: 10.4045/tidsskr.20.0993. [PubMed][CrossRef]
- 24.
Lebrun-Frenay C, Kantarci O, Siva A et al. Radiologically isolated syndrome: 10-year risk estimate of a clinical event. Ann Neurol 2020; 88: 407–17. [PubMed][CrossRef]
- 25.
Høglund RA, Myro AZ, Zarnovicky S et al. A young woman with seizures, visual impairment, and paralysis. Tidsskr Nor Legeforen 2019; 139. doi: 10.4045/tidsskr.19.0122. [PubMed][CrossRef]